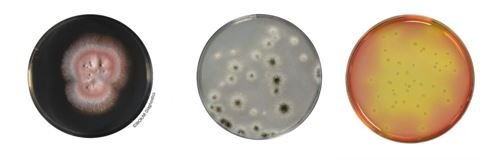
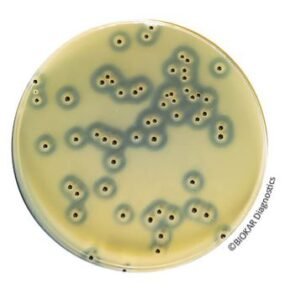
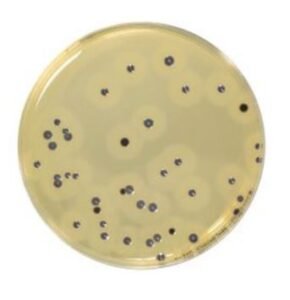
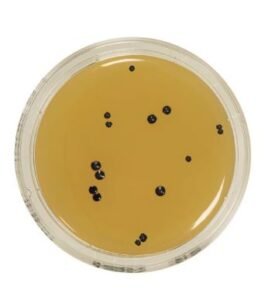
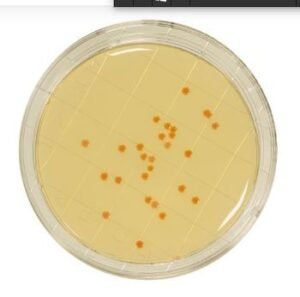
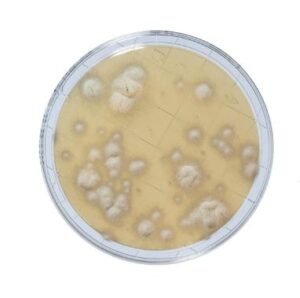
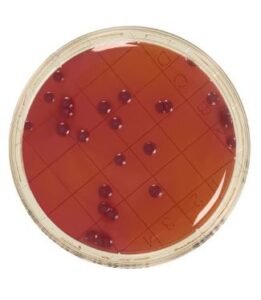
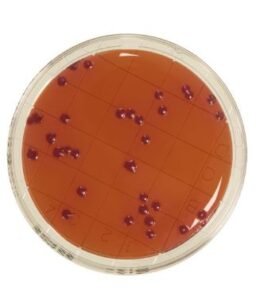
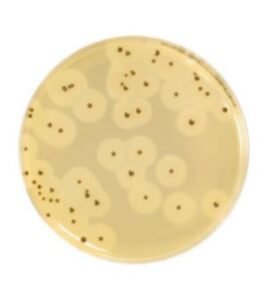
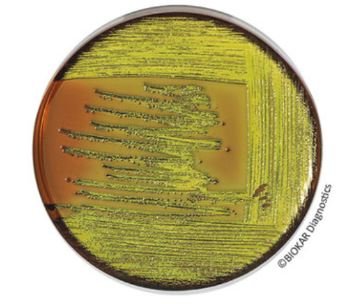
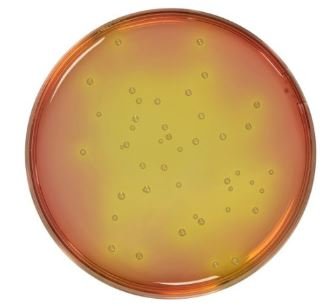
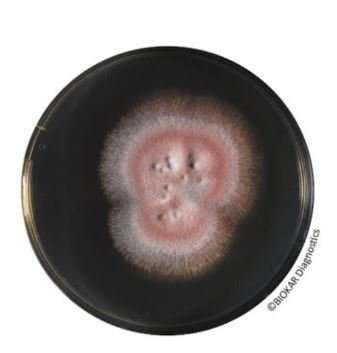
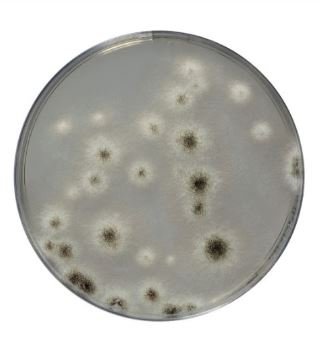

Baird-Parker Agar with egg yolk and potassium tellurite is a selective medium for the detection and enumeration of Staphylococcus aureus in animal origin biological samples, pharmaceutical products, cosmetics, foods and water.
Cosmetic
- Animal Health
- Cosmetic
- Food
- Rapid methods
- Water and environments
- Presentation
- Microorganism
Baird-Parker Agar With Egg Yolk Tellurite
Packaging
Ready-to-use medium :
BM01808 – 20 Petri plates Ø 90 mm
BM09108 – 120 Petri plates Ø 90 mm
Dehydrated base medium (without egg yolk or tellurite) :
BK055HA – 500 g bottle
BK055GC – 5 kg drum
Sterile Egg yolk emulsion with Potassium tellurite :
BS06008 – 10 vials of 50 mL
BS03608 – 1 vial of 900 mL
Sulfamethazine 25 mg supplement :
BS02808 – 10 vials qsp 500 mL
Baird-Parker RPF Agar
Baird Parker RPF (RPF = Rabbit Plasma Fibrinogen) Agar is used for the direct detection and enumeration of coagulase positive staphylococci. The medium has the advantage of considerably reducing the number of confirmation tests for the presence of coagulase positive staphylococci particularly when atypical colonies are observed on other selective media. The medium allows the simultaneous enumeration and confirmation to be performed in a single operation.
Packaging
Ready-to-use medium :
BM06708 – 20 Petri plates Ø 90 mm
BM15908 – 20 Petri plates Ø 55 mm
KIT :
BT00508 – 6 vials of 90 mL of base media and 6 RPF freeze-dried supplements
BT01008 – 6 vials of 190 mL of base media and 6 RPF freeze-dried supplements (BS075)
Dehydrated base medium :
BK055HA – 500 g bottle
BK055GC – 5 kg drum
Rabbit Plasma Fibrinogen Supplement :
BS03408 – 8 vials qsp 100 mL
BS03808 – 1 vial qsp 500 mL
Buffered Peptone Broth With Sodium Chloride (Ph 7,0)

Buffered Peptone Broth with sodium chloride pH 7.0 is a diluent used to prepare stock solutions or suspensions of water-soluble or non-lipid water-insoluble pharmaceutical products. The medium is also used to rinse membranes when the filtration method is used to enumerate bacteria, yeasts and molds on the surface of appropriate agar media. The diluent can also be used for stock solutions in the normalized methods for microbiological analysis of cosmetic products.
Packaging
Dehydrated medium :
BK128HA – 500 g bottle
Buffered Peptone Water

Buffered Peptone Water is a general use diluent destined for numerous operations and standards including sample preparation, the preparation of stock suspensions and serial dilutions of samples.
This media is also used for the pre-enrichment of Salmonella and for Cronobacter sakazakii, by allowing the resuscitation of microorganisms having undergone sublethal treatments as in the case of spray drying, pasteurization, action of conservators, elevated osmotic pressure and high acidity.
It is used as a suspension and resuscitation media for the enumeration of Listeria monocytogenes.
Packaging
Ready-to-use medium:
BM05608 – 50 tubes of 9 mL
BM05708 – 10 vials of 90 mL
BM01008 – 10 vials of 225 mL
BM13108 – 3 flexible bags of 3 L
BM13208 – 2 flexible bags of 5 L
BM21408 – 40 flexible bags of 5 L
Dehydrated medium (20.0 g/L):
BK131HA – 500 g bottle
BK131GC – 5 kg drum
Dehydrated medium (25.5 g/L):
BK018HA – 500 g bottle
BK018GC – 5 kg drum
Buffered Peptone Water Halal (BPW Halal)

Buffered Peptone Water is a general use diluent destined for numerous operations and standards including sample preparation, the preparation of stock suspensions and serial dilutions of samples (standard ISO 6887).
This media is also used for the pre-enrichment of Salmonella and for Cronobacter sakazakii, by allowing the resuscitation of microorganisms having undergone sublethal treatments as in the case of spray drying, pasteurization, action of conservators, elevated osmotic pressure and high acidity (NF EN ISO 6579-1, ISO 22964…).
The medium is certified Halal by Halal Feed and Food Inspection Authority (HFFIA), The Hague, Netherlands.
Packaging
Dehydrated media :
BK242HA – 500 g bottle
BK242GC – 5 kg drum (on demand)
Cetrimide Agar

Cetrimide Agar is a selective medium for the isolation and enumeration of Pseudomonas aeruginosa in biological samples of animal origin and in pharmaceutical and cosmetic products.
Its typical composition is that of the Pharmacopoeia and of the NF EN ISO 22717 for the control of cosmetic products.
Packaging
Ready-to-melt medium :
BM18408 – 10 vials of 100 mL
Dehydrated medium :
BK049HA – 500 g bottle
Chloramphenicol Selective Supplement 50 Mg

The Chloramphenicol Selective Supplement 50 mg, supplied as a lyophilized preparation, inhibits the development of most bacterial contaminants, thereby favoring the isolation of yeasts and molds.
The supplement can substitute for the Oxytetracycline supplement recommended in the routine
The supplement can also be added to Sabouraud Agar, (BK025), to obtain Sabouraud Chloramphenicol Agar, which also exists in complete dehydrated form (BK007).
Packaging
Freeze-dried supplement:
BS02108 – 10 vials
Coagulase Rabbit Plasma

Rabbit Plasma recovered over EDTA and freeze-dried is used for the detection of staphylocoagulase.
Its use is recommended in the standards NF EN ISO 6888-1 & NF EN ISO 6888-3; NF V08-057-1; and NF EN ISO
22718.
Packaging
Freeze-dried supplement:
BR00208 – 10 vials (20 reactions per vial)
Contact Baird-Parker + Neutralizers
Packaging
Ready-to-use medium :
BM21108 – 20 plates of Ø 65mm
Contact PCA + TTC + Neutralizers
Plate Count Agar (PCA) supplemented with TTC and neutralizers is a ready-to-use media. The media is used for the detection and enumeration of microorganisms present on surfaces by impression on agar to control critical points in industry (examples: protected areas, microbiological monitoring programs of surfaces and industrial environments).
Packaging
Ready-to-use medium :
BM20608 – 20 plates of Ø 65mm
Contact Sabouraud With Chloramphenicol (SDCA) + Neutralizers
Sabouraud with Chloramphenicol Agar, supplemented with neutralizers, is a ready-to-use media. The media is used for the detection and enumeration of yeasts and molds present on surfaces by impression on agar to control critical points in industry (examples: protected areas, microbiological monitoring programs of surfaces and industrial environments).
Packaging
Ready-to-use medium :
BM21008 – 20 plates of Ø 65mm
Contact VRBG + Neutralizers
VRBG agar (Violet Red Bile Glucose/Dextrose) with neutralizers is a ready-to-use media. The media is used for the detection and enumeration of Enterobacteriaceae, but also for the detection of Gram-negative and bile salt resistant bacteria present on surfaces by impression on agar to control critical points in industry (examples: protected areas, microbiological monitoring programs of surfaces and industrial environments).
Packaging
Ready-to-use medium :
BM20708 – VRBG – 20 plates of Ø 65mm
Contact VRBL + Neutralizers
VRBL agar (Violet Red Bile Lactose) with neutralizers is a ready-to-use media. The media is used for the detection and enumeration of coliforms and thermotolerant coliforms present on surfaces by impression on agar to control critical points in industry (examples: protected areas, microbiological monitoring programs of surfaces and industrial environments).
Packaging
Ready-to-use medium :
BM20908 – VRBL – 20 plates of Ø 65mm
Easy Staph Agar®
EASY STAPH is an alternative method for the enumeration of coagulase positive Staphylococci in food products, in animal feeds and in environmental samples. Devoid of the need for confirmation, the method allows count of pathogenic staphylococci in 22 hours instead of the usual 48 hours in the case of the standardized method NF EN ISO 6888-2. The media support the use of surface inoculation, in depth or by the Spiral method.
For all products destined for human consumption, the method is certified NF VALIDATION, under the Attestation N°BKR 23/10 – 12/15.
Packaging
EASY STAPH ready-to-use :
BM18708 – 20 Petri plates Ø 90 mm
BM19008 – 120 Petri plates Ø 90 mm
EASY STAPH supplement :
BS09008 – 8 vials qsf 100 mL
BS09708- 1 vial qsf 500 mL
EASY STAPH KIT :
BT01208 – 6 vials of 190 mL of base media + 6 freeze-dried supplements
BT01308 – 6 vials of 90 mL of base media + 6 freeze-dried supplements
EMB Agar (Levine)
EMB Agar, originally recommended by Levine, is used to isolate and identify enterobacteria (notably E. coli and Enterobacter aerogenes) in pharmaceutical, cosmetic and food products as well as water.
It is also used as a confirmation media for E. coli in cosmetic products.
Packaging
Dehydrated medium :
BK056HA – 500 g bottle
Eugon LT 100 Agar

Eugon LT 100 agar is used for the enumeration of total mesophilic aerobic microorganisms in cosmetic products with or without preservatives. It enables luxuriant colonies to form in the case of most microorganisms.
Packaging
Dehydrated medium :
BK138HA – 500 g bottle
Kligler Iron Agar

Kligler Iron Agar is used for the identification of enterobacteria by the rapid detection of lactose and glucose fermentation (with or without gas production), as well as the production of hydrogen sulfide.
Dehydrated medium :
BK034HA – 500 g bottle
Eugon LT 100 Broth

Eugon LT 100 broth is used as a neutralizing diluent and as an enrichment media for microorganisms in cosmetic products with and without preservatives.
The typical formula corresponds to that defined in all the cosmetic standards cited as references in the bibliography.
Packaging
Ready-to-use medium :
BM00608 – 50 tubes of 9 mL
BM04308 – 10 vials of 100 mL
Dehydrated medium :
BK137HA – 500 g bottle
Eugon LT Sup Broth

Eugon LT SUP broth is used as a neutralizing diluent and as an enrichment medium for mesophilic aerobic bacteria in cosmetic products with and without preservatives.
This broth substitutes the Eugon LT 100 broth, cited in the reference standards related to the microbiology of cosmetic products.
It does not contain Octoxynol 9, nor other products classified as CMR in the REACH regulation.
Packaging
Ready to use media :
BM22208- 10 x 100 mL
BM21908 – 50 x 9 mL tubes
BM22408 – 50 tubes x 9 mL tubes + glass balls
BM22908 – 3 x 3 L flexible bags
Lactose Broth

Lactose Broth is used principally as a liquid enrichment media for the detection of E. coli in cosmetic products, if neutralizers or dispersal agents are not necessary. It is also adapted to the culture of all Gram negative bacteria. Armed with a Durham tube, it can detect the fermentation of lactose.
Packaging
Dehydrated medium :
BK082HA – 500 g bottle
MacConkey Broth Purple

MacConkey Broth Purple complies with the formula described in the European Pharmacopoeia for the detection of E. coli in non-sterile products.
The media may be also used as a presumptive medium for the detection of coliform bacteria in water, milk, and seafood (oysters).
Packaging
Dehydrated medium :
BK107HA – 500 g bottle
Mannitol Salt Agar
Mannitol Salt agar is used for the selective isolation, detection and enumeration of pathogenic staphylococci in filterable water as in swimming pools, potable water or spas. It is also used for the detection of Staphylococcus aureus according to the Pharmacopeia and in cosmetic products.
Packaging
Dehydrated medium :
BK030HA – 500 g bottle
Non-Animal MRS Broth

The Non-Animal version of MRS broth is used primarily for the growth of lactobacilli or lactic acid bacteria via industrial fermentation for use as starter cultures in varying food, cosmetic or pharmaceutical products. By substituting all animal peptones with non-animal equivalents, the regulatory and safety concerns arising from bovine spongiform encephalothopy and related pathologies can be successfully eliminated, making the medium an ideal fermentative formula providing excellent growth
Dehydrated medium:
BK176HA – 500 g bottle
Nutrient Broth

Nutrient Broth is a general usage medium for a large variety of microorganisms without particular nutritional requirements.
Packaging
Dehydrated medium :
BK003HA – 500 g bottle
Potato Dextrose Agar (PDA)

Potato Dextrose Agar (PDA) is recommended in standards applied to cosmetic products. It can be used as selective media after addition of chloramphenicol or for applicability trials.
This media is also adapted to the growth of yeasts and molds.
Packaging
Ready-to-melt medium :
BM18608 – 10 vials 200 mL
Dehydrated medium :
BK095HA – 500 g bottle
Sabouraud Dextrose Agar (SDA)
Sabouraud Dextrose Agar is a classical medium for the culture, isolation and identification of yeasts & molds in sterility tests of pharmaceutical and cosmetic products. It is also used in the specific detection of Candida albicans in pharmaceutical products.
Packaging
Ready-to-use medium :
BM17308 – 20 Petri plates Ø 90 mm
Ready-to-melt medium :
BM05308 – 10 vials of 200 mL
Dehydrated medium :
BK025HA – 500 g bottle
Sabouraud Dextrose Broth

Sabouraud Dextrose Broth is recommended for the detection of Candida albicans in non-sterile products according to the harmonized Pharmacopeia.
It is also used as a nutrient media for the growth of yeasts and molds.
Packaging
Dehydrated medium :
BK026HA – 500 g bottle
Dextrose Chloramphenicol Agar (SDCA)
Sabouraud Dextrose chloramphenicol Agar (SDCA) is recommended for the isolation and the enumeration of yeasts and molds, especially when the samples are highly contaminated with bacteria. It is also used as selective isolation media for Candida albicans in cosmetic products.
Packaging
Ready-to-use medium:
BM17608 – 20 Petri plates Ø 90 mm
Ready-to-melt medium:
BM17208 – 10 vials of 200 mL
Sterile Distilled Water

Sterile distilled water is a diluent used for the rehydration of freeze-dried supplements.
It is also used in the detection and enumeration of E. coli and for intestinal enterococci in sea water by the microplate method.
Packaging
Ready-to-use medium:
BM11508 – 50 tubes of 18 mL
BM19408 – 10 vials of 90 mL
Symphony Agar

Symphony agar allows the enumeration of yeasts and molds in all human and animal food products regardless of their water activity. It can also be used for the control of environmental samples in production areas. In the case of water samples, they can be analyzed by membrane filtration using this media.
The SYMPHONY agar is certified by NF VALIDATION for the enumeration of yeasts and molds in all human and animal food products under the reference number BKR 23/11-12/18.
This method allows the enumeration after only 54 hours instead of 5 days with standard methods NF ISO 21527-1 and NF ISO 21527-2.
Packaging
Ready-to-use medium :
BM20208 – 20 Petri plates Ø 90 mm
Ready-to-melt medium :
BM19108 – 10 vials of 200 mL
Dehydrated medium :
BK227HA – 500 g vial
Thioglycolate Broth With Resazurin

Thioglycolate Medium with Resazurin is used for sterility tests of biological products and for the culture of aerobic, anaerobic and microaerophilic bacteria. This medium is also used for the confirmation of Clostridium perfringens in food products.
Packaging
Ready-to-use medium:
BM08208 – 50 tubes of 10 mL
Dehydrated medium:
BK017HA – 500 g bottle
Thioglycolate Broth with Resazurin Halal (FTM Halal)

Thioglycolate Medium with Resazurin Halal is used for sterility tests of biological products and for the culture of aerobic, anaerobic and microaerophilic bacteria. The typical composition corresponds to that defined in European (EP), United States (UP) and Japanese (JP) Pharmacopeias, and the AOAC for the bacteriological analysis of antibiotics and the determination of the sporicidal effect of disinfectants. The manufacturing protocol and the rigorous selection of solidification agents allow the special transparency of this media.
The medium is certified Halal by Halal Feed and Food Inspection Authority (HFFIA), The Hague, Netherlands.
Packaging
Dehydrated media :
BK245HA – 500 g bottle
BK245GC – 5 kg drum
Thioglycolate Broth with Resazurin Halal (FTM Halal)

Thioglycolate Medium with Resazurin Halal is used for sterility tests of biological products and for the culture of aerobic, anaerobic and microaerophilic bacteria. The typical composition corresponds to that defined in European (EP), United States (UP) and Japanese (JP) Pharmacopeias, and the AOAC for the bacteriological analysis of antibiotics and the determination of the sporicidal effect of disinfectants. The manufacturing protocol and the rigorous selection of solidification agents allow the special transparency of this media.
The medium is certified Halal by Halal Feed and Food Inspection Authority (HFFIA), The Hague, Netherlands.
Packaging
Dehydrated media :
BK245HA – 500 g bottle
BK245GC – 5 kg drum